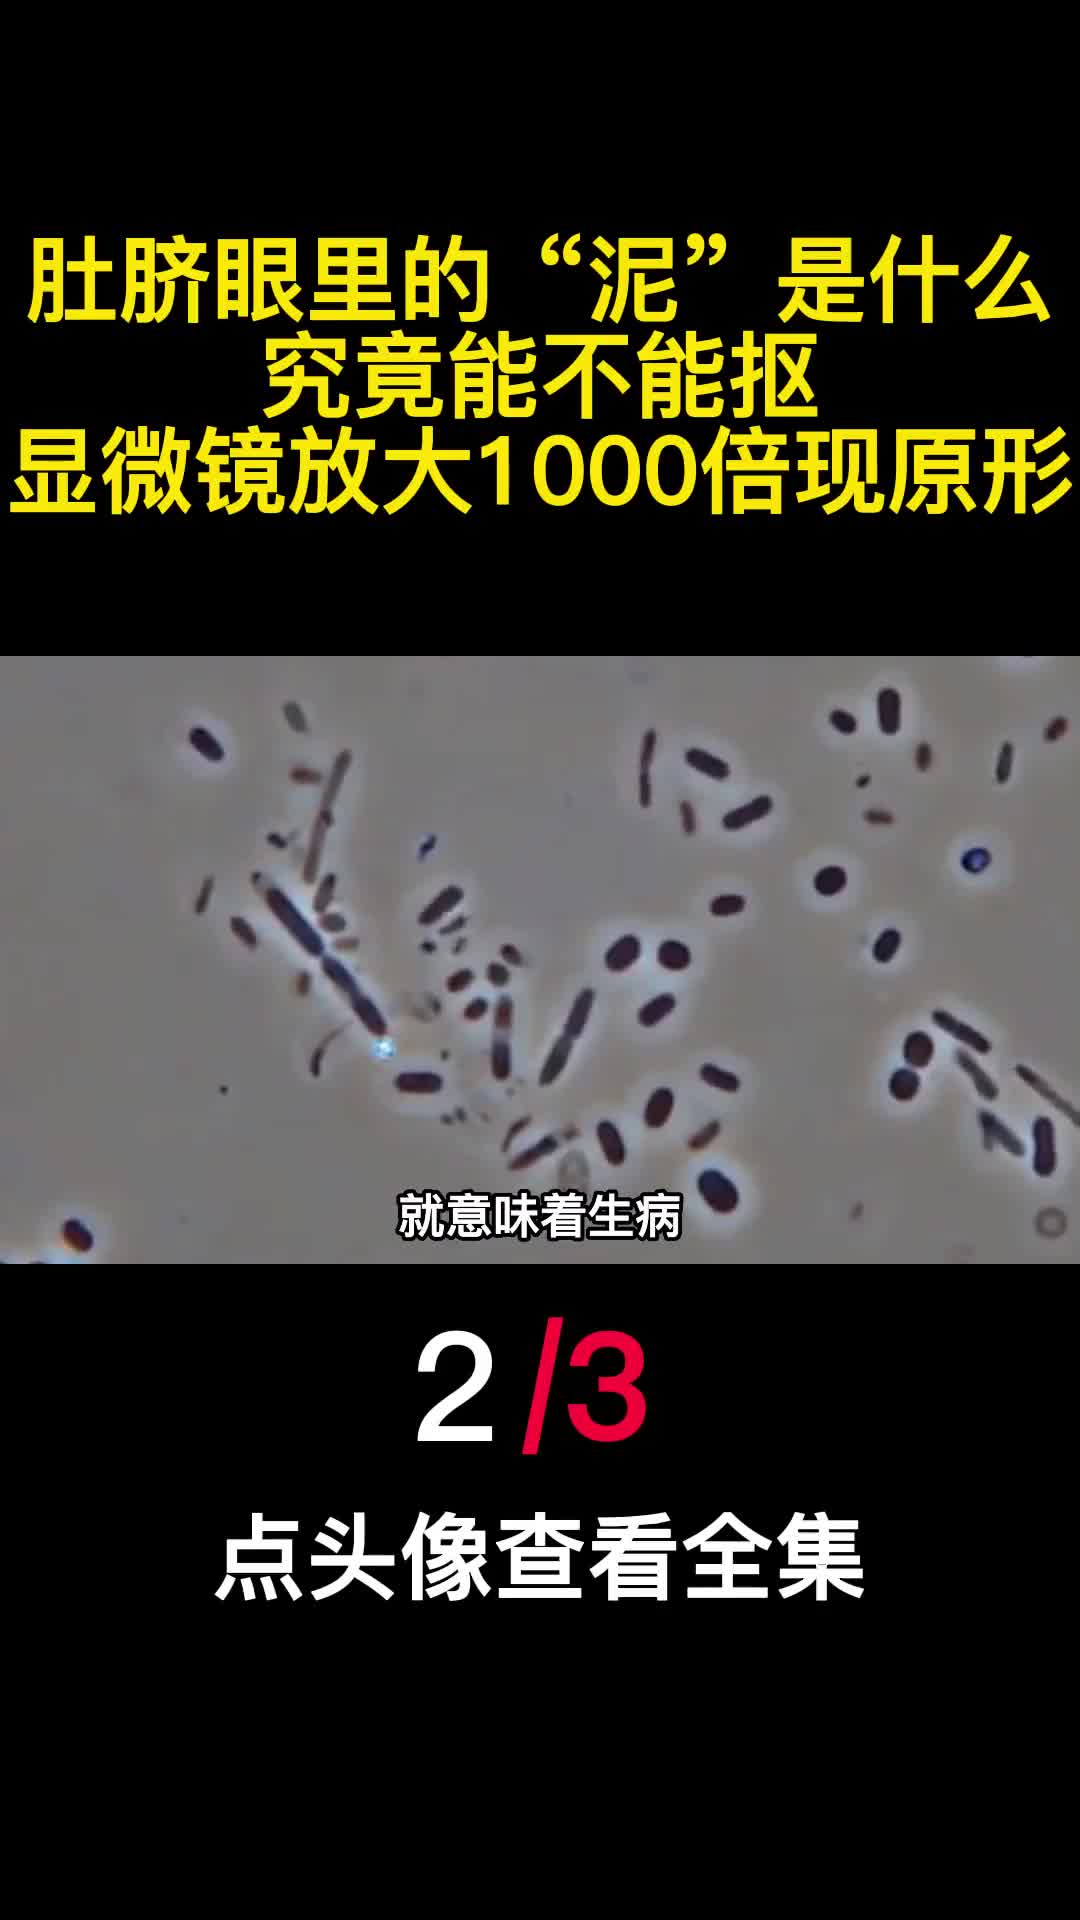
肚脐眼里的泥是什么究竟能不能抠显微镜放大1000倍现原形2

-
 肚脐眼里的泥是什么究竟能不能抠显微镜放大1000倍现原形3
肚脐眼里的泥是什么究竟能不能抠显微镜放大1000倍现原形3 -
肚脐眼里的泥是什么究竟能不能抠显微镜放大1000倍现原形2
肚脐眼里的泥是什么究竟能不能抠显微镜放大1000倍现原形2 -
 肚脐眼里的泥是什么究竟能不能抠显微镜放大1000倍现原形2
肚脐眼里的泥是什么究竟能不能抠显微镜放大1000倍现原形2 -
 肚脐眼里的泥是什么究竟能不能抠显微镜放大1000倍现原形1
肚脐眼里的泥是什么究竟能不能抠显微镜放大1000倍现原形1 -
 肚脐眼里的泥是什么究竟能不能抠显微镜放大1000倍现原形1
肚脐眼里的泥是什么究竟能不能抠显微镜放大1000倍现原形1 -
 肉贩子卖肉的时候为啥总用抹布擦拭猪肉其实不是因为干净
肉贩子卖肉的时候为啥总用抹布擦拭猪肉其实不是因为干净 -
 肉贩子卖肉的时候为啥总用抹布擦拭猪肉其实不是因为干净2
肉贩子卖肉的时候为啥总用抹布擦拭猪肉其实不是因为干净2 -
 肉贩子卖肉的时候为啥总用抹布擦拭猪肉其实不是因为干净2
肉贩子卖肉的时候为啥总用抹布擦拭猪肉其实不是因为干净2 -
 肉贩子卖肉的时候为啥总用抹布擦拭猪肉其实不是因为干净1
肉贩子卖肉的时候为啥总用抹布擦拭猪肉其实不是因为干净1 -
 肉贩子卖肉的时候为啥总用抹布擦拭猪肉其实不是因为干净1
肉贩子卖肉的时候为啥总用抹布擦拭猪肉其实不是因为干净1 -
 肉贩子卖肉的时候为啥总用抹布擦拭猪肉其实不是因为干净
肉贩子卖肉的时候为啥总用抹布擦拭猪肉其实不是因为干净 -
 聪明人买排骨时看到这四种转头就走肉贩子从不让家人吃3
聪明人买排骨时看到这四种转头就走肉贩子从不让家人吃3 -
 聪明人买排骨时看到这四种转头就走肉贩子从不让家人吃3
聪明人买排骨时看到这四种转头就走肉贩子从不让家人吃3 -
 聪明人买排骨时看到这四种转头就走肉贩子从不让家人吃2
聪明人买排骨时看到这四种转头就走肉贩子从不让家人吃2 -
 聪明人买排骨时看到这四种转头就走肉贩子从不让家人吃2
聪明人买排骨时看到这四种转头就走肉贩子从不让家人吃2 -
 聪明人买排骨时看到这四种转头就走肉贩子从不让家人吃1
聪明人买排骨时看到这四种转头就走肉贩子从不让家人吃1 -
 聪明人买排骨时看到这四种转头就走肉贩子从不让家人吃1
聪明人买排骨时看到这四种转头就走肉贩子从不让家人吃1 -
 联合国曾17次降半旗致哀中国独占6次看一看你认识几位3
联合国曾17次降半旗致哀中国独占6次看一看你认识几位3 -
 联合国曾17次降半旗致哀中国独占6次看一看你认识几位2
联合国曾17次降半旗致哀中国独占6次看一看你认识几位2 -
 联合国五常想退出五常会被一票否决权否决吗答案出乎意料2
联合国五常想退出五常会被一票否决权否决吗答案出乎意料2 -
 联合国五常想退出五常会被一票否决权否决吗答案出乎意料2
联合国五常想退出五常会被一票否决权否决吗答案出乎意料2 -
 联合国五常想退出五常会被一票否决权否决吗答案出乎意料1
联合国五常想退出五常会被一票否决权否决吗答案出乎意料1 -
 联合国五常想退出五常会被一票否决权否决吗答案出乎意料1
联合国五常想退出五常会被一票否决权否决吗答案出乎意料1 -
 耗资超2亿美元打造普京座驾有多牛能抵御重机枪和导弹袭击3
耗资超2亿美元打造普京座驾有多牛能抵御重机枪和导弹袭击3







